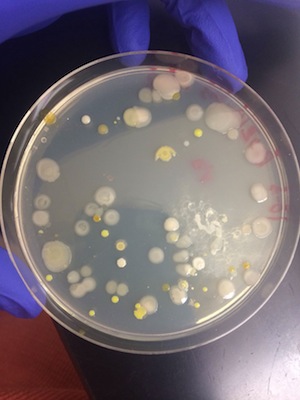
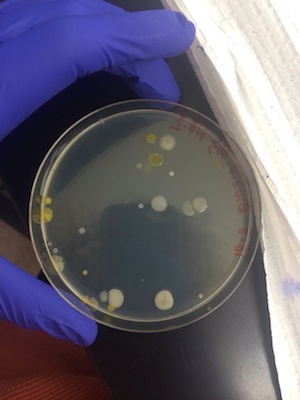
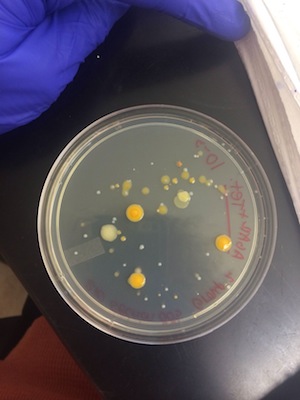
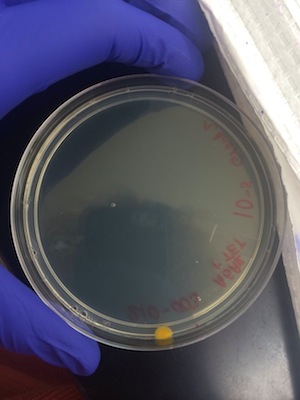

User:Claudia J. Woloshchuk/Notebook/Biology 210 at AU
Thursday, February 26th, 2015: 16s Sequencing
Purpose: The purpose of sending off the PCR set up from the bacterial samples taken from the agar plates created from our wildlife transect, was to ID the specific bacteria that lived in that transect.
Methods: In order to ID the bacteria and create the 16s sequencing a single colony of bacteria form the agar plates was transferred to 100 μL of water in a sterile tube. This was then incubated at 100 °C for 10 minutes in a heat block. Nest the samples were centrifuged for 5 minutes at 13,400 rpm. During the centrifuge, 20 μL of primer and water mixture was added to a PCR tube and mixed until the PCR bead was dissolved. 5 μL of the supernatant form the centrifuged samples was transferred to the 16s PCR reaction and placed in the PCR machine. The following week the PCR products were run on an agarose gel. Two of the most visible PCR products DNA was purified for sequencing and then sent off to be sequenced. This sequencing amplified the 16s rRNA gene, which is the gene sequence that is diverse and specific to each species. Thus, allowing us to use the sequence in a program called Blast which finds the species that corresponds to that specific sequencing.
Results:
Figure 1: agarose gel with PCR samples

MB43 (16s Sequence from Agar plate with Nutrient 10^-5): GGNNNNNNNNNNNNNNNNANNNTGCAGTCGTACAGGTAGCCGTAANTTGCTCTCGGGTGACGAGTGGCGGACGGGTGANT AATGTCTGGGAAACTGCCTGATGGAGGGGGATAACTACTGGAAACGGTAGCTAATACCGCATAACGTCGCAAGACCAAAG AGGGGGACCTTCGGGCCTCTTGCCATCAGATGTGCCCAGATGGGATTAGCTAGTAGGTGGGGTAATGGCTCACCTAGGCG ACGATCCCTAGCTGGTCTGAGAGGATGACCAGCCACACTGGAACTGAGACACGGTCCAGACTCCTACGGGAGGCAGCAGT GGGGAATATTGCACAATGGGCGCAAGCCTGATGCAGCCATGCCGCGTGTATGAAGAAGGCCTTCGGGTTGTAAAGTACTT TCAGCGGGGAGGAAGGTGTTGTGGTTAATAACCGCAGCAATTGACGTTACCCGCANAANAAGCACCGGCTAACTCCGTGC CAGCANCCGCGGTAATACGGANGGTGCAAGCGTTAATCGGNAATTACTGGGCGTAAAAGCGCACGCAGGCGGTCTGTCAA GTCGGATGTGAAANTCCCCCGGGCTCAACCTGGGAACTG
MB44 (16s Sequence from Agar Plate with Nutrient and Tetracycline 10^-3): NNNNNNNNNNNNNNNNCNNNNNNNNGACAGCCGAGCGGTAGAGATCTTTCGGGATCTTGAGAGCGNGCGNTACGGGTGCG GANCNNNTGTGCAACCTGCCTTTATCAGGGGGATAGCCTTTCGAAAGGAAGATTAATACCCCATAATATATTGAATGGCA TCATTTGATATTGAAAACTCCGGTGGATAGAGATGGGCACGCGCAAGATTAGATAGTTGGTAGGGTAACGGCCTACCAAG TCAGTGATCTTTAGGGGGCCTGAGAGGGTGATCCCCCACACTGGTACTGAGACACGGACCAGACTCCTACGGGAGGCAGC AGTGAGGAATATTGGACAATGGGTGAGAGCCTGATCCAGCCATCCCGCGTGAAGGACGACGGCCCTATGGGTTGTAAACT TCTTTTGTATAGGGATAAACCTTTCCACGTGTGGAAAGCTGAAGGTACTATACGAATAAGCACCGGCTAACTCCGTGCCA GCAGCCGCGGTAATACGGAGGGTGCAAGCGTTATCCGGATTTATTGGGTTTAAAGGGTCCGTAGGCGGATCTGTAAGTCA GTGGTGAAATCTCATAGCTTAACTATGAAACTGCCATTGATACTGCAGGTCTTGAGTAAANGTANAAGTGGCTGGAATAA GTANTGTANCGGTGAAATGCATAGATATTACTTANAACACCNATTGCGANNCAGGTCACTATGNTTTAACTGACGCTGAT GGACGAAAGCGTGGGGAGCGAACNGGATTANATACCCTGGGTAGTCCACGCCGTAAACNATGCTAACTCGTTTTTGGNCT TTAGGGTTCAGANACTAAACNAAAGTGATNAGTTAAGCCNCCTGGGGANTACGTTCGCAAGAATGAAACTCANAGGAATT GAACGGGGGCCCGCACACCGGGGGATTATGTGGTTTANTNNNATNANTCNCANGGAACCNTACCANGCTAAATGGGNATT GANGGGTNNNNANTAGACTTTCTTCNANNNTTTCAANGNNCTNCATGGGTGGNNGNGNGCTNNNGCNNNNAAGNNNNNNN N
MB43 Species ID: Enterobacteriaceae Bacterium S2A 16s ribosomal RNA gene, 97% match
MB44 Species ID: uncultured bacterium clone, 95% match
Conclusion: In conclusions, the 16s sequencing of MB43 which ID the species as Enterobacteriaceae Bacterium S2A corresponds to the data we collected on the bacteria during the gram staining procedure and colony morphology. This bacterial species is gram negative and forms a convex, round and smooth colony. The bacteria is also seen to be rod shaped which is what we saw form the gram staining as well (http://www.uniprot.org/taxonomy/1465543). The 16s sequencing of the bacterial sample of MB44, however was poor quality, which therefore produced only a 95% match to a uncultured bacterium clone. This is a broad conclusion and therefore not much information was found on this bacteria and we had nothing to compare our data from the gram sating procedure to. This could be due to the sample quality of the original bacterial sample from the agar plate. This sample also came from an agar plate with tetracycline on it, which is another possible reason for the poor quality of the 16s sequencing.
-C.W.
4.7.15 Good entry. The tetracycline wouldn't have effected the sequencing. SK
Thursday, February 19th, 2015: Zebra Fish Development
Purpose: The purpose of this lab is to see how environmental conditions affect embryonic development. Ethanol is specifically used in my groups experiment, as an environmental condition. The hypothesis is that is ethanol is added to a zebrafish embryo, the development of the zebrafish will be affected. We predict that the ethanol will cause a higher death rate, smaller eye diameter and slower heart rate among developing zebrafish.
Materials and Methods: In order to test this hypothesis that ethanol will affect the development of zebra fish, three different petri dishes were made. One as a control with 20 mLs deerpark water, another with a solution of 0.75% ethanol, and a last one with a solution of 0.375% ethanol. Next, twenty healthy, translucent zebrafish eggs were added to each petri dish very carefully using a dropper. These three sets of zebra fish were then observed under a microscope to determine what developmental stage they were at as of that moment. Lastly the petri dishes were set aside in a safe place to grow and develop over the course of the next few days. On Monday February 23rd each of the three petri dishes of Zebrafish were observed again to determine how many eggs had died, how many were still alive, how big they were, what developmental stage, if there is any movement and if possible to measure the eye diameter and heart rate. In addition the solution the eggs are in was refreshed. This observation and solution refreshing process was repeated 3 more times on Feb 26th, March 2nd and March 5th. At the end of the two week period, we observed the zebra fish that were still alive to assess the if the ethanol had any affect on the development of the fish.
Data and Observations:
Table 1: Zebra Fish Embryos in Water (control group)
| ' | Day 0 | Day 4 | Day 7 | Day 11 | Day 14 |
| Dead eggs | 0 | 10 | 2 | 6 eggs | 0 |
| Number surviving | 20 | 10 | 6 eggs, 2 hatched | 2 hatched | 2 hatchlings |
| remove | nothing | 20 mL water | 10 mL water, dead eggs | 10 mL water, dead eggs | nothing |
| add | 20 mL Water | 25 mL water | 10 mL fresh water | 10mL fresh water | nothing |
| length | N/A | N/A | 4 mm | 4 mm | 1.) 4 mm, 2.) 4.5 mm with fins |
| developmental stage | oblong to sphere | 2 fish, others are bud stage | 20 somite, fish are 48 hour hatched | hatched | hatched |
| movement | N/A | fish are swiftly moving using tales | fish are swiftly moving using tails | subtly movement, eyes move a lot | tail, slow, eyes move a lot |
| eye diameter | N/A | 0.2 mm | 0.5 mm, head is 0.75 mm | 0.5 mm, head is 0.75 mm | 0.5 mm |
| heart rate | N/A | N/A | 66 beats per minute | 70 beats per minute | 78 beats per minute |
Table 2: Zebra Fish Embryos in 0.75% Ethanol Solution
| ' | Day 0 | Day 4 | Day 7 | Day 11 | Day 14 |
| Dead eggs | 0 | 9 | 8 | 0 | 3 hatchlings |
| Number surviving | 20 | 11 | 3 hatched | 3 hatched | 0 |
| remove | nothing | 20 mL solution | 10 mL solution | 10 mL of solution | nothing |
| add | 10 mL 1.5% ethanol 10 mL water | 25 mL solution | 10 mL solution | 5 mL ethanol, 5 mL water | nothing |
| length | N/A | N/A | 4 mm | 4 mm | 4 mm |
| developmental stage | oblong to sphere | 2 fish, the rest are bud stage | 48 hour | hatched, greener than the control group | black |
| movement | N/A | fish are swiftly moving through solution using tails | using tails | quick, random movement | none |
| eye diameter | N/A | N/A | 0.25 mm | 0.25 mm, head is 1 mm | none |
| heart rate | N/A | N/A | 36 beats per minute | 45 beats per minute | none |
Table 3: Zebra Fish Embryos in 0.375% Ethanol Solution
| ' | Day 0 | Day 4 | Day 7 | Day 11 | Day 14 |
| Dead eggs | 0 | 3 | 7 | 3 | 2 eggs dead, 1 hatchling |
| Number surviving | 20 | 17 | 4 fish, 6 eggs | 4 hatched, 2 eggs | 3 hatchlings |
| remove | nothing | 20 mL solution | 10 mL solution | 10 mL solution, dead eggs | nothing |
| add | 5 mL 1.5 % ethanol 15 mL water | 25 mL solution | 10 mL solution | 2.5 mL ethanol, 7.5 mL water | nothing |
| length | N/A | N/A | 5 mm | 5mm | 5 mm |
| developmental stage | oblong to sphere | 3 fish, the rest are in bud stage | 48 hour hatched | hatched, darker body cavity | hatchling with larger body cavity |
| movement | N/A | fish are swiftly moving through solution using tails | tails | quicker than control group, random movement | rapid random movement, can't stay still |
| eye diameter | N/A | 0.2 mm | 0.25 mm | 0.5mm head is 1 mm | 0.5 eye diameter, head is 1.5 mm |
| heart rate | N/A | N/A | 36 beats per minute | 36 beats per minute | 60 beats per minute |
Conclusion: In conclusion the hypothesis that the ethanol would affect zebra fish development was correct. At the time of the start of the experiment the embryos were 24-36 hours old, thus they were mainly in the oblong to sphere stage of development and two weeks later the surviving embryos had developed into hatchlings. As they developed each group of zebra fish developed into hatchlings of different sizes with the control group being 4 mm and the 0.375% ethanol being 5 mm. The group with 0.75% ethanol also had a higher death rate than the control group. In both groups with ethanol the fish developed eyes with a smaller diameter than the fish in the control group and their heart beat was significantly lower than the control group (see tables 1-3). Some potential errors with this experiment are mainly based off of human error with respect to measurement of size and heartbeat.
-C.W.
2.20.15 Excellent entry. Good description of Berlese funnel and invertebrates found in transect. Nice food web and data table of vertebrates. SK
Thursday, February 12, 2015: Lab 5: Invertebrates
Purpose: The purpose of this lab was to understand the importance of the invertebrates roll in the larger ecosystem and in addition, to learn how simple systems evolved into more complex systems. The hypothesis is that the invertebrates collected from the transect from last lab, will include: mites, springtails, small beetles, nematode worms and spiders.
Materials and Methods: In order to understand the importance of invertebrates, prepared slides/petri dishes of invertebrates were observed and characterized with a dissecting microscope. These organisms included a Planaria, nematodes, annelida and a few types of arthropods. Next, a Berlese funnel, which was prepared a week before using leaf litter and a small amount of soil from the groups assigned transect, was broken down. The top 10-15 mLs of liquid and organisms in the conical tube was poured into a petri dish. This petri dish was then observed under a dissecting microscope for any organisms. These organisms were then measured, identified and recorded. Finally, vertebrates were observed within their natural habit of the groups transect, which was a wildlife habitat.
Data and Observations:
Table 1: Transect 2 Invertebrates
| Organism (phylum and class) | Length in mm | Number in Sample | Description of Organism |
| Arachnida Spider | 0.5 | 1 | small, almost colorless, a bit brown, eight legs, arthropods |
| Microanthropod, small Beetle | 1.5 | 2 | pale yellow, jointed legs, exoskeleton, more than one body section, protosomes |
| Annelid Worm | 2 | 1 | clear, two body openings, simple nervous system, protosomes, coelomate |
Table 2: Vertebrates in Transect 2: Wildlife Habitat
| Type of Vertebrate | Phylum-species | Benifical Biotic Factors of Transect | Benifical Abiotic Factors of Transect |
| Hawk | bird, accipiter cooperii | smaller vertebrates/invertabrates to eat, trees to rest in | shadows to hide in and be protected from the sun |
| Robin | bird, thrushes, turdus migratorius | smaller vertabrates/invertabrates, trees | signs to rest on, benches |
| Gray Squirrel | rodent, sciuridae, sciurus carolinensis | nuts and berries to eat, trees to climb, plants to hide in | benches to sit on |
| Rat | rodent, muriodea | plants and seeds to eat, plants to hide in | soil to hide in |
| Chipmunks | rodent, sciuridae | seeds and berries to eat, trees to climb, plants to hide in | soill to dig in |
Image 3: Food Web of All Organisms in Transect 2

Conclusion:
In conclusion the hypothesis that the invertebrates collected from the transect would include mites, springtails, small beetles, nematode worms and spiders, was partially correct. We did find small beetles, spiders and worms. The data from table 1 supports this conclusion. The size range of organisms that we found was 0.5 mm- 2 mm. The annelid worm was the largest at 2 mm. The spider was the smallest at 0.5 mm, although at this time the legs were shriveled up, so if the spider was alive it may have been the largest. The small beetle was the most common found in the leaf litter. From this small sample it was found twice. In the prepared slides that were observed one was a Planaria which is an acoelomate with a simple whip like movement. This shows that the body structure is a small body, flatworm. The second organism was a Nematode, which is a pseudocoelom round worm with undulations. An annelida was then observed, which is a coelomate with a bendy retraction movement which shows its fluid filled cavity. Lastly, vertebrates from our transect were looked for as seen in Table 2. Squirrels, chipmunks, rats, a Hawk, and a Robin were observed. A Food web as seen in image 3, based on all of the organisms that were found in Transect 2 was made. All of these organisms represent the ecological concept of community because this transect has a wide variety of species living together. They also represent a carrying capacity because the Transect was only a small piece of the greater environment. Only a certain number of each species were found. The trophic levels of each organism that was found is shown in the food wed (image 3). Each organism is benefitting the other which helps the environment and community that these organisms are living in to thrive.
-C.W.
2.20.15 Excellent notebook entry. Nice table of results and good detailed descriptions. SK
Thursday, February 5, 2015: Lab 4 Plant and Fungi
Purpose: The purpose of this lab was to understand the characteristics and diversity of plants and to learn the importance and function of fungi. The hypothesis is that there would be a variety of plant types within my groups transect including: non vascular plants, seedless plants, gymnosperms seed plants and angiosperm seed plants.
Materials and Methods: In order to understand the characteristics and diversity of plants, five plant samples with taken from the transect. These plant samples were then dissected and observed under a microscope to identify the vascularization, size and shape, specialized structures and mechanisms of reproduction. In addition to these plant samples, sample slides that were prepared before the lab of Bryophyte moss, Mnium, and an angiosperm, Lilium were also dissected and observed for the same characteristics. A cross section of each plant was made in order to fully observe the plant characteristics. In order to learn the importance and function of fungi, prepared slides of Rhizopus Stolonifer (black bread mold) and mushrooms were observed for the sporangia, rhizoids, spores, hyphae and mycelium. A Berlese Funnel was also set up to collect invertebrates for next weeks lab.
Data and Observation:
Table 1: Transect Sample Plant Characteristics
| Transect sample plants | Location and # in transect | Description (size and shape) | Vascularization | Specialized Structures | Mechanisms of Reproduction |
| #1 | Red Berry tree by the bench | Small tree, no leaves, red berries, sample size= 15 cm | yes | branches, berries, roots | seeds,dicot, angiosperm |
| #2 | moss on ground by stepping rocks | 1 foot in diameter, cluster of green moss, sample size= 5 cm | no | rhizoids | Dependent on water, sperm swim from antheridium to the archegonium |
| #3 | Grass bushes west of transect | small bush with long skinny green leaves, sample size= 35 cm | yes | roots, leaves | seedless |
| #4 | tree with small buds south side of transect | small tree with brown leaves and buds, sample size= 24 cm | yes | branches, flowers/buds, roots | seeds, dicot, angiosperm |
| #5 | Plant growth, west side of transect | green small leaf shrub, sample size 13 cm | yes | roots, stem, leaves | seeds, dicot |
Conclusion:
In conclusion the hypothesis that there would be a wide variety of vegetation type in the transect was correct. The data from table 1 and images 1-5 support this conclusion. Plant number one was an angiosperm, plant number two was a non-vascular plant, plant number 3 was a seedless plant with vascularization, plant number 4 was an angiosperm, and plant number five was an angiosperm. The fungi observed can be seen in images 6 and 7. Image 6 is the Mushroom which is a Basidiomycota and Image 7 is the Rhizopus Stolonifer (black bread mold) which is a zygomycota. The Black Bread Mold has sporangia which are the small, dark, globe like structures growing upward and are made up of hyphae. These sporangia give the Black Bread Mold its name and also carry spores which release when the sporangia open and allow the fungi to reproduce. These fungi are characterized by their specialized structures, such as the basidia on the mushroom and the hyphae, sporangia and rhizoids of the Black Bread Mold. The only element of this experiment would be human observation error, due to the fact that the lab was purely based off of observation.
-C.W.
2.9.15
Very good notebook entry. The formatting of the tables is disrupted in this format. Try http://excel2wiki.net to make your table in excel then copy and paste it into the website, covert it and then copy and paste the converted version into your notebook. SK
Thursday, January 29, 2015: Lab 3 Microbiology and Identifying Bacteria with DNA Sequences
Purpose: The purpose of this lab was to understand the characteristics of bacteria, to observe resistance and to understand how DNA sequences are used to identify species. The hypothesis is that bacteria will grow on the all of the agar plates, including the ones with tetracycline due to bacterial resistance. In addition, Archaea species will have grown on the agar plates because they tend to grow in extreme, isolated environments and the agar plates provide that.
Materials and Methods: In order to understand bacteria and observe resistance bacteria from the Hay Infusions were placed on 8 serial dilutions. Four of the serial dilutions had just an agar nutrient and the other four had agar nutrient and tetracycline. Therefore if any bacteria grew on the agar plates with tetracycline, it would be understood that that bacteria was antibiotic resistant. These plates were prepared one week before this lab was completed. The bacteria that had grown was observed and recorded, taking into account the dilution, agar type, colonies counted, and the colonies per mL. Bacteria cell morphology was the observed using the bacteria from the agar plates, including the plates with tetracycline if bacteria had grown. This was done by creating four wet mounts using two bacterial samples from the agar plates without tetracycline and two samples from the agar plates with tetracycline. To crete a wet mount one sterilizes a loop over a flame, scrapes a tiny amount of growth from the surface of the agar plate and mix it with a drop of water on a slide. Then place a cover slip over the slide. The bacteria was observed under a microscope at 10x and 40x. Then oil was used to observe the slides at 100x. Four gram statins were then made using bacteria samples from the same colonies within the agar plates. In order to prepare these slides one first sterilizes a loop over a flame, scrapes up a tiny amount of growth from the agar plate and mixes it with a drop of water on a slide. The pass the slide, bacterial smear side up through a flame three times. Next, working over a staining tray, cover the bacterial smear with crystal violet for 1 minute. Rinse the stain off with a bottle of water. Cover the bacterial smear with Gram's iodine mordant for 1 minute. Rinse the stain off using a bottle of water. Next, decolorize by flooding the bacterial smear with 95% alcohol for 10-20 seconds. Rinse gently with water. Then cover the smear with safranin stain for 20-30 seconds. Rinse the stain off with water. Blot the excess water carefully using a kimwipe. Coverslips were not used. This process was completed four times to make four slides. The slides were then observed using a microscope with 10x and 40x. Lastly, PCR set up was completed for 16s sequencing. In order to do this first transfer a single colony of bacteria to 100 μL of water in a sterile tube. THen incubate at 100 degrees celcius for 10 minutes in a heating block. Next centrifuge the samples for 5 minutes at 13,400 rpm. During the centrifugation, add 20 μL of primer/water mixture to a labeled PCR tube. Mix it to dissolve the bead. Lastly transfer 5 μL of supernatant from the centrifuged samples to the 16s PCR reaction and place the tube in the PCR machine. These was done 4 times with 4 different bacterial samples from the agar plates.
Data and Observation: One last observation of the Hay Infusion Culture was made. There was only 1 inch of water left which was filled with soil, berries, and moss. It still smelled rotten. The appearance and smell of the infusion may change week to week due to the growth and death of organisms within the infusion and due to the evaporation of the water.
Table 1: 100-fold Serial Dilutions Results Dilution Agar type Colonies Counted Conversion Factor Colonies/mL 10^-3 nutrient 64 x10^3 64,000 10^-5 nutrient 22 x10^5 2,200,000 10^-7 nutrient none x10^7 0 10^-9 nutrient none x10^9 0 10^-3 nutrient + tet 71 x10^3 71,000 10^-5 nutrient +tet 1 x10^5 100,000 10^-7 nutrient+tet none x10^7 0 10^-9 nutrient +tet none x10^9 0
Image 1: Agar plate 10^-3 without Tet
Image 2: Agar plate 10^-5 without Tet
Image 3: Agar plate 10^-3 with Tet
Image 4: Agar plate 10^-5 with Tet
Table 2: Bacteria Characterization Colony Label Plate type Colony Description Cell Description Gram + or - Additional Notes
10^-5 Nutrient Milky white, circular N/A - Large clumps/circular
Convex, smooth magnification=40x
10^-5 Nutrient Yellow, wavy edges, N/A - rods clumped together
convex, smooth magnification=40x
10^-3 Nutrient + Tet Yellow, round, convex Round shape + circular clumps
Smooth slow motility, magnification=40x
Clumped together
10^-3 Nutrient + Tet Milky white, circular Thread like, single - rods clumped together
Convex, smooth Moves fast, randomly magnification=40x
Conclusion:
In conclusion the plates with tetracycline grew bacterial growth including Archaea growth as hypothesized. The data as presented above supports this conclusion. The growths looked to be the same type of growths as on the plates without tetracycline (Images 1-4). Although the 10^-5 agar plate with Tetracycline had far fewer growths than the 10^-5 agar plate without Tet, the 10^-3 agar plate with Tet had more growths than the 10^-3 agar plate without Tet. This indicated that the bacteria that did grow was antibiotic resistant.The serial dilutions for 10^-7 and 10^-9 did not grow any growths (table 1). Tetracycline is a broad spectrum antibiotic which works by inhibiting cell growth by inhibiting translation. Tetracycline will bind to the 16S part of the 30S ribosomal subunit and prevent the amino-acyl tRNA from binding to the A site of the ribosome. Some bacteria that are sensitive to Tetracycline are gram-positive bacteria, gram-negative bacteria, chlamydiae, mycoplasmas, rickettsiae, and protozoan parasites, although more micro organisms are becoming resistant as shown in this experiment (http://www.ncbi.nlm.nih.gov/pmc/articles/PMC99026/). One thing that may have caused experimental error is human error. This is in relation to the number of colonies on the agar plates.
-C.W.
2.4.15 Nice detailed entry. Indicated where in Hay infusion obtained protists and included descriptions. Should be organized into Purpose, Methods etc. sections. SK
Thursday, January 22, 2015: Lab 2 Hay Infusion Culture
The Hay Infusion Culture, filled with soil and ground vegetation from the transect, smelled rotten (similar to a dirty fish tank). At the top of the jar there is floating berries, a wood chip and a layer of what looks like slime. This layer could be algae. At the bottom of the jar there is soil, moss, and some pieces of wood. In the middle of the jar there is dirty water with small bits of brown debris floating in it.
We took two samples for microscopic observation. One came from the very top layer of the jar with the layer of algae and the other came from near the moss at the bottom of the jar. The organisms may differ based on the location that we pulled samples form due to the fact that some organisms may prefer an area with more light and algae and others may prefer an area with more soil and plant matter.
From the wet mount made from the sample taken from the bottom of the jar we observed a Colpidium. This organism was motile, is a protozoa, non-photosynthesizing and consumes nutrients. It measured to be 26 μM. We found many of these organisms, around 20, on the slide that was made from the sample taken from the top of the jar as well.

From the wet mount made from the sample taken from the top of the jar we observed Gonium. This protozoa contained about 16 cells and was 20μM. Gonium are motile and are non photosynthesizing.

The Gonium that we found meets all the needs of life because it is alive. It is a live due to the fact that it acquires and uses energy, is made up of one or more cells (ours was made of 16 cells), it processes information, is capable of oogamous replication, and it is a product of evolution because it is part of the volvocine line.
If the Hay culture grew for another two months I predict that different organisms would develop and the organisms that were found already would grow, multiply and some would die.
One selective pressure that would affect the community of our samples would be the amount of sunlight let into the Infusion Jar, which would effect the photosynthesis of some organisms in the culture. Another selective pressure would be the variety of organisms living in the culture. A community needs a variety of organisms to go on and if organisms die off or were never there, this may be detrimental to the community.
-C.W.
1.27.15 Good first entry. For future entries try to organize lab book into: Purpose, Materials & methods, data & observations and conclusion future directions. You also need to address the red text from the manual. SK
Thursday, January 15, 2015: Lab 1 AU Transect
My lab group, Group 2, was assigned a 20 by 20 meter transect on American University's campus. The transect is located in between two sidewalks and a dorm building. It is part of a garden with benches, grass, many plants and trees.
Biotic components: trees, moss, bushes, shrubs, grass, berries Abiotic components: stepping stones, arboretum signs, shade from buildings, benches, pebbles, soil, the little bit of snow
-C.W.
Thursday, January 15, 2015: Observing Evolution
| Organism | Size | Reproduction | |
| chlamy | 10 | iso | |
| gonium | 50 | oo | |
| volvox | 214 | oo |
-C.W.

















